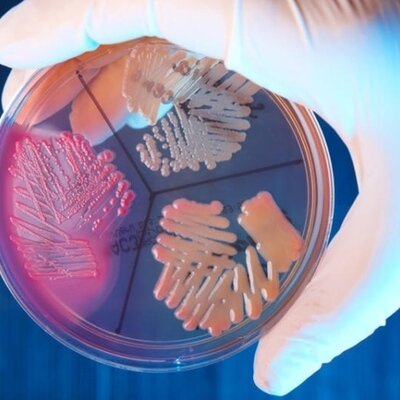
Presente

-
 Para expresar sus ideas sobre el origen de la enfermedad escribió en verso la obra Syphilis (sífilis o mal francés). Enfermedad de transmisión sexual se dispersaba mediante seres vivos invisibles (unas “semillas”) y por contacto íntimo. Después, describió el contagio de las enfermedades por contacto directo a través de las manos o la ropa, así como el “contagio a distancia” por “semillas” dispersadas por el aire.
Para expresar sus ideas sobre el origen de la enfermedad escribió en verso la obra Syphilis (sífilis o mal francés). Enfermedad de transmisión sexual se dispersaba mediante seres vivos invisibles (unas “semillas”) y por contacto íntimo. Después, describió el contagio de las enfermedades por contacto directo a través de las manos o la ropa, así como el “contagio a distancia” por “semillas” dispersadas por el aire. -
El microscopio, permitió la observación de unos “bichos diminutos”, de un mundo desconocido presente allí donde se mirara: aguas, suelos, cuerpos de animales, plantas, el propio organismo humano. Pero esta presencia produjo solamente un conocimiento derivado de la observación. Era un mundo nuevo, “invisible”. Los microorganismos existían, tenían una forma definida en el espacio y perduraban en el tiempo, pero sólo se les consideraba “curiosidades”. Esta etapa duró durante prácticamente 2 siglos.
-
 Fue un científico inglés. Fue un excelente microscopista. Publicó el libro Micrographia (1665), el primer libro dedicado a las observaciones microscópicas.
Fue un científico inglés. Fue un excelente microscopista. Publicó el libro Micrographia (1665), el primer libro dedicado a las observaciones microscópicas. -
 Fue un holandés vendedor de telas y aficionado a la microscopía. Construía microscopios muy simples con una sola lente. Llamó a los microorganismos «diminutos animálculos», las descubrió en 1676 mientras estudiaba infusiones de pimienta, fueron publicadas en 1684. Fue llamado "EL PRIMER CAZADOR DE MICROBIOS"
Fue un holandés vendedor de telas y aficionado a la microscopía. Construía microscopios muy simples con una sola lente. Llamó a los microorganismos «diminutos animálculos», las descubrió en 1676 mientras estudiaba infusiones de pimienta, fueron publicadas en 1684. Fue llamado "EL PRIMER CAZADOR DE MICROBIOS" -
 Gracias a sus investigaciones,le dieron el nombre de "biólogo de biólogos". Spallanzani confirmó que los organismos unicelulares son seres vivos.
Gracias a sus investigaciones,le dieron el nombre de "biólogo de biólogos". Spallanzani confirmó que los organismos unicelulares son seres vivos. -
La importancia de los microorganismos como causantes de las enfermedades infecciosas no fue bien conocida por la comunidad científica, ni mucho menos por la población en general, hasta bien avanzado el siglo XIX. Tradicionalmente se creía que las enfermedades eran consecuencia de fuerzas sobrenaturales (vapores venenosos o “miasmas”, un castigo divino), o del desequilibrio entre los cuatro humores del cuerpo humano (sangre, flema, bilis amarilla [cólera] y bilis negra [melancolía])
-
 Fue un químico, físico, matemático y bacteriólogo francés, cuyos descubrimientos tuvieron una enorme importancia en diversos campos de las ciencias naturales, sobre todo en la química y la microbiología. Refutó la teoría de la generación espontánea y reinterpretó la fermentación alcoholica. También desarrolló vacunas contra: rabia, cólera aviar y carbunco.
Fue un químico, físico, matemático y bacteriólogo francés, cuyos descubrimientos tuvieron una enorme importancia en diversos campos de las ciencias naturales, sobre todo en la química y la microbiología. Refutó la teoría de la generación espontánea y reinterpretó la fermentación alcoholica. También desarrolló vacunas contra: rabia, cólera aviar y carbunco. -
 Estudió las algas unicelulares y, más tarde, las bacterias.estaba especialmente interesado en la resistencia de las bacterias al calor, y su investigación le condujo al descubrimiento de la formación de endosporas por parte de algunas bacterias.
Estudió las algas unicelulares y, más tarde, las bacterias.estaba especialmente interesado en la resistencia de las bacterias al calor, y su investigación le condujo al descubrimiento de la formación de endosporas por parte de algunas bacterias. -
 Junto a Pasteur fueron los fundadores de la microbiología moderna. Koch anunció el descubrimiento del Mycobacterium tuberculosis, la bacteria que causa la tuberculosis. Desarrolló unos principios, o "postulados de Koch", que probaban irrefutablemente que un determinado organismo causaba una determinada enfermedad.
Junto a Pasteur fueron los fundadores de la microbiología moderna. Koch anunció el descubrimiento del Mycobacterium tuberculosis, la bacteria que causa la tuberculosis. Desarrolló unos principios, o "postulados de Koch", que probaban irrefutablemente que un determinado organismo causaba una determinada enfermedad. -
 Considerado el padre del uso clínico de los probióticos y del descubrimiento de cualidades beneficiosas para la salud en la fermentación de la leche observando que los lactobacilos transformaban la lactosa en ácido láctico, sustancia que actúa contra las bacterias patógenas. El trabajo que le valió el Premio Nobel y la inmortalidad como padre de la inmunología celular, fue el descubrimiento de la fagocitosis.
Considerado el padre del uso clínico de los probióticos y del descubrimiento de cualidades beneficiosas para la salud en la fermentación de la leche observando que los lactobacilos transformaban la lactosa en ácido láctico, sustancia que actúa contra las bacterias patógenas. El trabajo que le valió el Premio Nobel y la inmortalidad como padre de la inmunología celular, fue el descubrimiento de la fagocitosis. -
 Al realizar las autopsias a los soldados fallecidos por causa de estas fiebres, Bruce encontró en su bazo, su hígado y sus riñones un microoganismo que denominó Micrococcus melitensis y que demostró que provocaba la enfermedad. Luego pasó a llamarse Brucella melitensis en su honor.
Al realizar las autopsias a los soldados fallecidos por causa de estas fiebres, Bruce encontró en su bazo, su hígado y sus riñones un microoganismo que denominó Micrococcus melitensis y que demostró que provocaba la enfermedad. Luego pasó a llamarse Brucella melitensis en su honor. -
 Junto con Yersin publicó tres memorias sobre la difteria. En ellas aportaron la prueba definitiva de que el bacilo de Klebs-Löeffler era la causa de la enfermedad, que producía un veneno muy activo, la toxina, cuyas propiedades también estudiaron.
Junto con Yersin publicó tres memorias sobre la difteria. En ellas aportaron la prueba definitiva de que el bacilo de Klebs-Löeffler era la causa de la enfermedad, que producía un veneno muy activo, la toxina, cuyas propiedades también estudiaron. -
 Smith se dedicó a estudiar la fiebre de Texas, una enfermedad que debilita al ganado. En 1889, junto con el veterinario F. L. Kilbourne, descubrió la Babesia bigemina, el parásito protozoo transmitido por la garrapata que es responsable de la fiebre de Texas.
Smith se dedicó a estudiar la fiebre de Texas, una enfermedad que debilita al ganado. En 1889, junto con el veterinario F. L. Kilbourne, descubrió la Babesia bigemina, el parásito protozoo transmitido por la garrapata que es responsable de la fiebre de Texas. -
 La mayor contribución de Beijerinck al campo de la
La mayor contribución de Beijerinck al campo de la
microbiología fue su clara formulación de la técnica del cultivo de enriquecimiento. Así pudo aislar los primeros cultivos puros de muchos microorganismos edáficos y acuáticos. Recordado por el descubrimiento del virus del mosaico del tabaco. -
 Ross descubrió que cuando los parásitos jóvenes del estómago del mosquito se desarrollaban hasta alcanzar su madurez, se desgarraban, liberando organismos filiformes en el insecto, donde se dispersaban por la circulación. Ambos observaron que el parásito se estaba acumulando en la glándula salival del mosquito, que contenía el anticoagulante que inyecta antes de alimentarse. Así se descubrió el ciclo de vida del parásito de la Malaria.
Ross descubrió que cuando los parásitos jóvenes del estómago del mosquito se desarrollaban hasta alcanzar su madurez, se desgarraban, liberando organismos filiformes en el insecto, donde se dispersaban por la circulación. Ambos observaron que el parásito se estaba acumulando en la glándula salival del mosquito, que contenía el anticoagulante que inyecta antes de alimentarse. Así se descubrió el ciclo de vida del parásito de la Malaria. -
 Fue un destacado microbiólogo, ecólogo, edafólogo ruso, pionero de los conceptos de ciclos vitales. Descubridor del proceso biológico de la nitrificación, la primera etapa del conocimiento de la quimioautotrofía. Junto a Beijerinck exploró el suelo y el agua en busca de microorganismos que llevan a cabo importantes
Fue un destacado microbiólogo, ecólogo, edafólogo ruso, pionero de los conceptos de ciclos vitales. Descubridor del proceso biológico de la nitrificación, la primera etapa del conocimiento de la quimioautotrofía. Junto a Beijerinck exploró el suelo y el agua en busca de microorganismos que llevan a cabo importantes
procesos naturales. -
 Comienza la edad ECOLÓGICA de la microbiología. Estudiar Microorganismos in situ (relación con el ambiente). Fue pionero en el estudio de los microbios que viven y necesitan altas temperaturas, los hipertermófilos, al investigar los manantiales de aguas termales del Parque Nacional Yellowstone, en Estados Unidos.
Comienza la edad ECOLÓGICA de la microbiología. Estudiar Microorganismos in situ (relación con el ambiente). Fue pionero en el estudio de los microbios que viven y necesitan altas temperaturas, los hipertermófilos, al investigar los manantiales de aguas termales del Parque Nacional Yellowstone, en Estados Unidos.
La bacteria, acabaría revolucionando la biotecnología y haciendo posible los llamados tests PCR, las pruebas más fiables usadas en todo el mundo para diagnosticar la Covid-19. -
La ecología microbiana es una de las ciencias microbiológicas más destacadas del último cuarto del siglo XX. Aunque ya comenzaba con los trabajos pioneros de Martinus Beijerinck (1851–1931) y Sergei Winogradsky (1856–1952); el primer libro de texto con el nombre de ecología microbiana (Principles of Microbial Ecology, de Thomas D. Brock) no fue publicado hasta 1966. Siglo XXI hubo mucho desarrollo de microscopios y técnicas (cultivo in vitro, tincion, esterilización, etcétera).
-
En la actualidad, la microbiología se encuentra en un periodo de diversificación. Van surgiendo diversas ramas de estudio: exobiología, biología sintética, fagoterapia, etc. Lo que ofrece una amplia oportunidad de investigación y de desarrollo en tecnología.
En la actualidad, la microbiología se encuentra en un periodo de diversificación. Van surgiendo diversas ramas de estudio: exobiología, biología sintética, fagoterapia, etc. Lo que ofrece una amplia oportunidad de investigación y de desarrollo en tecnología.
Looking for a timeline maker?
Create timelines for projects, roadmaps, history, lessons, legal cases, and stories with Timetoast. Timetoast is a timeline maker for work, school, research, and stories.